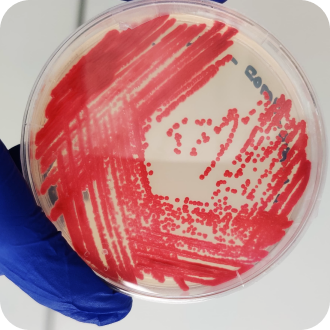

Who we are?
EPIC Lab is a comprehensive, one-stop laboratory offering services in measurement, monitoring, degradation analysis, toxicity testing, treatment solutions, and policy guidance for all types of plastic materials — including micro- and nano plastics, recycled plastics, plastic-associated chemicals, and bioplastics.
We maintain complete independence and is recognized by major global certification bodies for its expertise in (bio)degradability and composability. Our research has directly informed policy reforms, contributing to improved plastic waste management and the development of sustainable material alternatives.